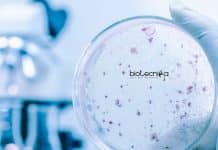
CSIR-IICB Microbiology Project Associate Vacancy Available CSIR-IICB Microbiology Project Associate

Banaras Hindu University Research Fellow Vacancy – Applications Invited
Banaras Hindu University Research Fellow Vacancy - Applications Invited
Banaras Hindu University Research Fellow Vacancy - Applications Invited. BHU, Varanasi is hiring for research position....
ICGEB Drug-Resistance Tuberculosis Project Job For Biological Sciences
ICGEB Biological Science JRF/SRF Job - Applications Invited
ICGEB Biological Science JRF/SRF Job - Applications Invited. MSc Biological Science candidates are encouraged to apply for...
ICMR-NIRRH Staff Recruitment For COVID-19 Work – Apply Online
NIRRH Vacancies For Biotech/Biochem/Life Science & Microbiology
NIRRH Vacancies For Biotech/Biochem/Life Science & Microbiology. NIRRH recruitment for bsc/msc biotech, biochem, life science and microbiology candidates....
CSIR-IICB Microbiology Project Associate Vacancy Available
CSIR-IICB Microbiology Project Associate Vacancy Available
CSIR-IICB Microbiology Project Associate Vacancy Available. MSc Microbiology/ Botany/ Zoology jobs for eligible candidates at CSIR-IICB. CSIR-IICB Jobs -...
Scientists Find New Insights Into Common Cold Virus Blocking The Influenza Virus
One Respiratory Virus Can Block Another Virus's Infection: Study Finds
According to a study by scholars at Yale University, it is indicated that through the...
Govt IBSD Anti-SARS-CoV-2 Activity Project Job For Life Sciences
Govt IBSD Research Jobs For Life Science - Rs. 48,000 pm Pay
Govt IBSD Research Jobs For Life Science - Rs. 48,000 pm Pay. MSc...
Self-Check Kiosk To Detect & Prevent COVID-19 By IIT Guwahati’s Researchers
Self-check Kiosk To Detect And Prevent COVID-19
As steadily the public lockdown measures as easing down and people are returning to normal life, the demand...
Researchers Develop Computer-Designed Antiviral Proteins Inhibiting SARS-CoV-2 in The Lab
Computer-designed Antiviral Proteins Inhibit SARS-CoV-2 in The Lab
Scientists have now shown computer-designed small proteins protecting lab-grown human cells from the COVID-19 causing coronavirus, the...
An Open Letter Signed To Question The ‘Unlikely-patterns’ Found In Russian COVID Vaccine Data
'Strange-patterns' found in Russian COVID vaccine data: Scientists
An open letter doubting the safety of the information presented in the early-stage trial outcomes of the...
Lack of Oxygen Found to Trigger Metastases in Cancer
Lack of Oxygen Trigger Metastasis in Cancer
The spread of cancer from the place it originally formed to another part of the body is called...
Focus Area Science Technology Summer Fellowship [FAST-SF] – 2021
Focus Area Science Technology Summer Fellowship 2021 -
Focus Area Science Technology Summer Fellowship 2021 - . Indian Academy of Sciences, Bengaluru/ Indian National...
Summer Research Fellowship Programme for Students and Teachers 2021
Summer Research Fellowship Programme 2021 - IAS, INSA & NASI
Summer Research Fellowship Programme 2021 - IAS, INSA & NASI. Indian Academy of Sciences, Bengaluru/...
Biotecnika Times – Newsletter 11.09.2020 – CSIR-CCMB & IGIB Recruitment, Ferrero Food Tech
Biotecnika Times - CSIR-CCMB & IGIB Recruitment, Ferrero Food Tech
CSIR-CCMB Biological Sciences Project Associate Recruitment – Apply Online
CSIR-CCMB Biological Sciences Project Associate Recruitment –...
Ferrero Food Technology Production Officer Recruitment 2020
Ferrero Rocher Jobs 2020 - Food Technology Apply Online
Opportunity for Indian nationals to work at Ferrero Rocher. Ferrero Rocher Jobs 2020 - Food Technology...
Pfizer Microbiology Advisor Job Opening – Apply Online
Pfizer Microbiology Advisor Job Opening - Apply Online
Pfizer Microbiology Advisor Job Opening - Apply Online. Pfizer is hiring MSc Microbiology candidates for Medical Advisor,...

![Focus Area Science Technology Summer Fellowship [FAST-SF] – 2021 Focus Area Science](https://www.biotecnika.org/wp-content/uploads/2020/09/Focus-Area-Science-218x150.jpg)








